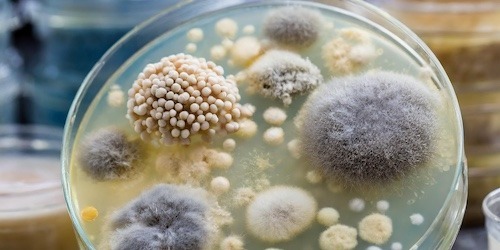

Pandemic Laboratory Preparedness
SciLifeLab has been commissioned by the government to build laboratory capacity to assist in future pandemics (program 2021-2028).
Explore pandemic preparedness projects
Over 30 projects have been funded by the Pandemic Laboratory Preparedness in multiple funding calls since 2021. Click the ‘funded projects’ button below to view all of the projects funded to date. It is possible to find out more about each project by clicking on the card related to it. In some cases, a poster related to the project is also available for viewing.









Background
In December 2020, SciLifeLab was commissioned by the government to build capacity to be equipped to assist in future pandemics, supported with additional governmental funding to SciLifeLab (40 MSEK in 2021 and 30 MSEK per year 2022-2024, in total 130 MSEK), Research proposition Prop. 202/21:60. The assignment was to through research (focused on diagnostics, analysis of infection, immunity, and resistance development related to viruses, bacteria and other disease-causing organisms), competence and technology development (focused on sequencing, genetic analysis, immunological methods and management of big data) optimize SciLifeLab operations to support and complement other societal functions such as authorities, municipalities and regions in pandemic laboratory preparedness. The development of these activities should take place in consultation with the Swedish Public Health Agency (FoHM).
To meet these aims, SciLifeLab invited PIs and collaborators to submit Letters of Intent, LOIs, for proposals on how SciLifeLab should develop services and capabilities to detect and monitor COVID-19, and how to manage and develop pandemic preparedness, in a national open call. Ideally these capabilities will be developed by the SciLifeLab infrastructure, alternatively, the suggestions could include proposals for new SciLifeLab infrastructure services.

The evaluation criteria were the scientific weight of the proposed capabilities, the research group’s scientific level, possible implementation of the proposal, relevance to the management of COVID-19 and other pandemics over the next two years and for long-term use in pandemic research, importance for SciLifeLab and interaction with units and plans for management and sharing of data generated within the proposed capability.
The review was initiated by a prescreening of the LOIs, performed by SciLifeLab’s Management group to identify which suggestions that best align with SciLifeLab’s mission and cover the preparedness for pandemics, where eight LOIs were selected for the continuation of the process. The eight selected LOIs were discussed with FoHM (Folkhälsomyndigheten) to confirm their importance in Pandemic Laboratory Preparedness. In follow-up interviews with the scientific lead, coordinator of PLP and the SciLifeLab co-director, the responsible PIs and collaborators of the eight LOI were given guidelines for submission of a complete application according to an adjusted budget and with suggested collaborators. The complete applications were evaluated by the SciLifeLab Management group and external reviewers and they were also discussed with FoHM. The selected capabilities are supposed to work as a collaborative network integrated into the SciLifeLab infrastructure to form a stable platform for SciLifeLab’s pandemic laboratory preparedness (See figures).

The components of the Pandemic Laboratory Preparedness network.
Plans going forward
Eight primary focus areas have been defined for SciLifeLab towards future work in Pandemic Laboratory Preparedness:
- Focus on research support – research is needed during pandemics
- Support and coordinate team-science efforts during pandemics
- Support techniques and technology development important for the study of pandemic pathogens and their effects
- Operate nationally and in collaboration with other research infrastructures
- Work to facilitate the flow of patient samples to infrastructure platforms
- Support data management, sharing and open publication during pandemics
- Support training in pandemic laboratory preparedness
- Make a permanent investment in pandemic laboratory preparedness within SciLifeLab
Contact persons
Scientific lead for the SciLifeLab Pandemic Laboratory Preparedness is Staffan Svärd and Jessica Alm.
Coordinator for the Pandemic Laboratory Preparedness capability is Alice Sollazzo, alice.sollazzo@scilifelab.uu.se. Please reach out with any questions.